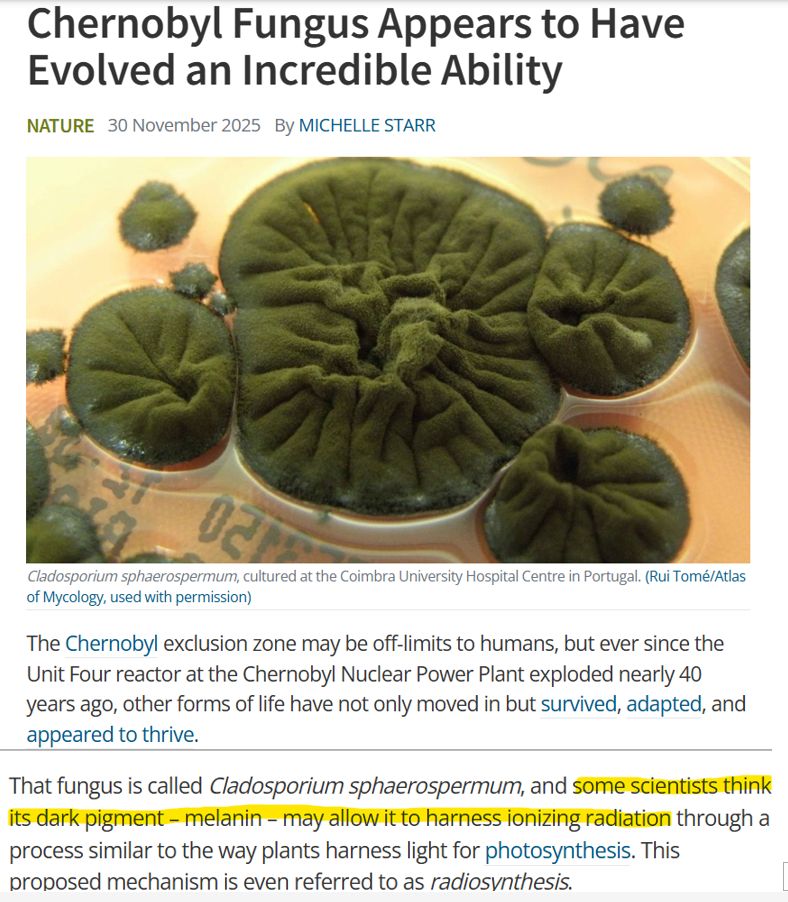

Then he ran away.
Then he ran away.
www.cnbc.com/2025/06/04/a...

www.cnbc.com/2025/06/04/a...
No Dem presidential candidate wins w/o high Black turnout & vote.
So stop making it like Black voters are expendable or that you can serve up any candidate chosen by Pelosi, Clooney or MSM & win.
No Dem presidential candidate wins w/o high Black turnout & vote.
So stop making it like Black voters are expendable or that you can serve up any candidate chosen by Pelosi, Clooney or MSM & win.



www.nytimes.com/2025/03/16/m...


Levi Strauss & Co.
Head of Talent, Diversity & Inclusion - GPO
"Cultivating a diverse and inclusive workplace"
"It’s not just the right thing to do — it’s a business imperative. We know that companies are stronger and more successful when they are diverse and inclusive."

Levi Strauss & Co.
Head of Talent, Diversity & Inclusion - GPO
"Cultivating a diverse and inclusive workplace"
"It’s not just the right thing to do — it’s a business imperative. We know that companies are stronger and more successful when they are diverse and inclusive."
Now is a time for courage.
www.cnn.com/2025/02/16/p...

Now is a time for courage.
www.cnn.com/2025/02/16/p...
1. Both political parties are not equally evil
2. Not voting for a candidate because you don't agree with their stance on one single issue is naïve. Because
3. To make anything better (or worse) you have to be in power

1. Both political parties are not equally evil
2. Not voting for a candidate because you don't agree with their stance on one single issue is naïve. Because
3. To make anything better (or worse) you have to be in power

Support their work. www.democracydocket.com/member-me/
Support their work. www.democracydocket.com/member-me/





